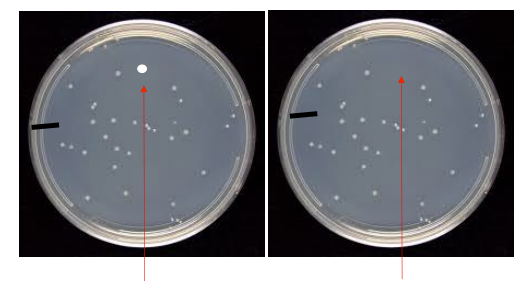
<p>in the spots where the colonies are whats the fitness, and where they are not whats the fitness</p>

1/42
Looks like no tags are added yet.
Name | Mastery | Learn | Test | Matching | Spaced | Call with Kai |
|---|
No analytics yet
Send a link to your students to track their progress
Change in the genetic make-up of a population over time
evolution
Time is _____
generational
Change in allele frequency can
take place ____ in certain
environment/population
conditions. You will observe this
during your lifetime.
quickly
groups of individuals of the same species.
populations
Way to tell something is peer-reviewed
Data? Tables and graphs?
• Listed authors and affiliations?
• Abstract?
• DOI number?
• Volume number and maybe issue?
• References
• Cited by other scientific articles
Mission statement
E. coli is a ____
ubiquitous Bacteria
environment of e coli
Tryptic Soy Agar
what temp does e coli grow at
37⁰C
• Discard gloves in ____ bins at front of lab.
autoclave
what was the name of the antibiotic we used for the evolution lab
Tetracycline
the change in genetic variation (allele
frequencies) in a population over
_____ time.
evolution, generational
AMP parameters that are usually the same
Fitness of Genotypes AA, Aa, aa
• Population Size
• Number of Generations
• Number of Populations (Replicates run at the same time)
• Initial p(A)
• Mutation Rates (leave at zero unless directly testing)
CHANGE ONLY 1 VARIABLE
Hardy Weinberg Requirments
The population is large enough to be unaffected by random gene changes.
There is no gene flow (immigration or emigration).
No mutations occur or there is mutational equilibrium.
There is random mating. Allele fitness
There is no natural selection. Allele fitness
Hardy weingberg equation and what each thing represents

Replica plating order
high, low, control
How do antibiotics cause resistance?
Select bacteria that
reproduce (fitness > 1
& remove bacteria that
do not reproduce
(fitness =0)
Induce mutations that
confer antibiotic
resistance.
____ is a driver of evolution
natural selection
__ changes in fitness can have __ effects
small, big
3 facts about mutations
Mutations are often deleterious.
Mutations are often neutral
Mutations are sometimes beneficial
whats needed for natural selection
variation
Loss of alleles through random chance. Unpredictable.
Genetic drift (happens in small populations)
allele loss = ___ of other alleles
fixation
draw what genetic equilibrium looks like


whats happening in the top row (model 1) and the bottom row (model 2)
Model 1
Pre-existing variation. Colonies in high
are also in low antibiotic plates
Model 2
Antibiotics induce mutation. Colonies
arise in higher antibiotic concentrations
in the spots where the colonies are whats the fitness, and where they are not whats the fitness
where they are = 1
where they are not = 0
What is a homologous trait?
A.Two tissues that have the same function and
the same evolutionary lineage.
B.Two tissues that have
the same evolutionary lineage.
What are analogous traits?
Similar function but evolved independently and different structure
Trees built with homologous traits are ____
predictive
note: Less dependent on which trait you choose to use first
how r trees built/based on
Historic Trees:
Current Trees:
Phenotypes, genotypes
draw the phylogenetic tree of bacteria, archaea, eukarya

draw the evolutionary relationships between the Three Domains of Life and the various Kingdoms of Eukarya.

__________ distinguish plants from archaea & bacteria
Intracellular structures
______ distinguishes plants from protists
Multicellular
______ distinguishes plants from animals and fungi: _____
Nutrition mode, autotrophic
Plants had a gradual evolution with clear trends.
___ mya algae
____ mya land plants
___ mya vascular plants
___ mya origin of seeds
___ mya flowers
1500, 475, 420, 300, 120
draw a phylogenetic tree representing land plants’ vasculature

kingdom of plants
plantae
whats all of the phyla of plantae
Hepatophyta
Bryophyta
Lycophyta
Monilophyta
Cycadophyta
Ginkgophyta
Coniferophyta
Anthophyta
Plants can exist as ____ or ____
haploid, diploid

sporophyte (diploid, vascular)

Gametophyte (haploid, non-vascular)